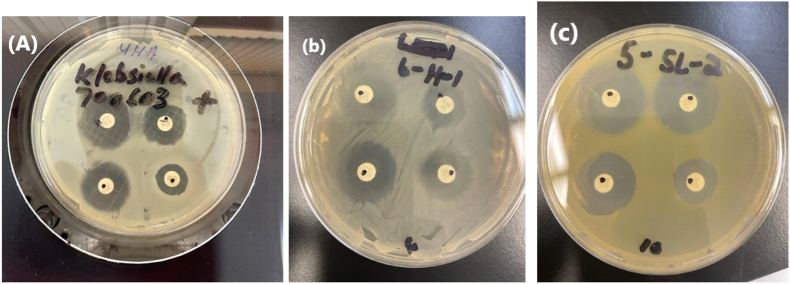

Bacterial burden and drug-resistant bacteria in healthcare workers' mobile phones: a study in Puerto Rican outpatient clinics
IF 1.9
Q3 INFECTIOUS DISEASES
引用次数: 0
Abstract
Background
Mobile phones used by healthcare workers (HCWs) in hospitals are significant reservoirs of drug-resistant bacteria responsible for hospital-acquired infections (HAIs).
Aim
The objective of this study was to assess the level of contamination with such bacteria in outpatient clinics.
Methods
Swabs from 83 HCWs' mobile phones were processed using standard biochemical and enzymatic procedures to identify pathogenic bacteria. β-Lactamase tests, antimicrobial susceptibility tests, screening for extended-spectrum β-lactamase (ESBL), and carbapenemase production were performed according to CLSI guidelines. Molecular detection of multi-drug-resistant genes (mecA in Staphylococcus aureus and kpc/ndm carbapenemases in Klebsiella pneumoniae and Acinetobacter spp.) was performed using multiplex real-time polymerase chain reaction.
Findings
The overall prevalence of mobile phone contamination with one or more bacteria was 100%. A total of 51 Gram-positive and 44 Gram-negative isolates, including 20 coagulase-negative staphylococci (CoNS), 20 S. aureus (0 meticillin-resistant S. aureus), 11 Acinetobacter spp. and 10 K. pneumoniae were isolated. β-Lactamase production was detected in 45% of CoNS and 30% of S. aureus. Panton–Valentine Leukocidin (PVL) toxin gene in S. aureus was found in 20% (4/20) of the isolates. Twenty (20%) and 13% of the Acinetobacter spp. and K. pneumoniae isolates, respectively, were ESBL but not carbapenemase producers.
Conclusions
The presence of HAI-causing organisms on mobile phones used by HCWs in outpatient clinics necessitates the implementation of infection control measures to mitigate the risk of cross-contamination in critical healthcare settings.

卫生保健工作者移动电话中的细菌负担和耐药细菌:波多黎各门诊诊所的一项研究。
背景:医院卫生保健工作者(HCWs)使用的移动电话是导致医院获得性感染(HAIs)的耐药细菌的重要宿主。目的:本研究的目的是评估这类细菌在门诊诊所的污染水平。方法:采用标准生化和酶法对83例医护人员手机拭子进行病原菌鉴定。根据CLSI指南进行β-内酰胺酶试验、抗菌药敏试验、广谱β-内酰胺酶(ESBL)筛选和碳青霉烯酶生产。多重耐药基因(金黄色葡萄球菌中的mecA、肺炎克雷伯菌和不动杆菌中的kpc/ndm碳青霉烯酶)采用多重实时聚合酶链反应进行分子检测。研究结果:手机被一种或多种细菌污染的总体发生率为100%。共分离到革兰氏阳性和革兰氏阴性葡萄球菌51株和44株,其中凝固酶阴性葡萄球菌20株、金黄色葡萄球菌20株(耐甲氧西林金黄色葡萄球菌0株)、不动杆菌11株和肺炎克雷伯菌10株。在45%的con和30%的金黄色葡萄球菌中检测到β-内酰胺酶的产生。20%(4/20)的金黄色葡萄球菌检出潘通-瓦伦丁白细胞介素(PVL)毒素基因。20株(20%)和13%的不动杆菌和肺炎克雷伯菌分离株为ESBL,但不产生碳青霉烯酶。结论:卫生保健工作者在门诊诊所使用的手机上存在导致hai的微生物,因此有必要实施感染控制措施,以减轻关键卫生保健机构交叉污染的风险。
本文章由计算机程序翻译,如有差异,请以英文原文为准。
求助全文
约1分钟内获得全文
求助全文
来源期刊

Infection Prevention in Practice
Medicine-Public Health, Environmental and Occupational Health
CiteScore
4.80
自引率
0.00%
发文量
58
审稿时长
61 days
 求助内容:
求助内容: 应助结果提醒方式:
应助结果提醒方式:


